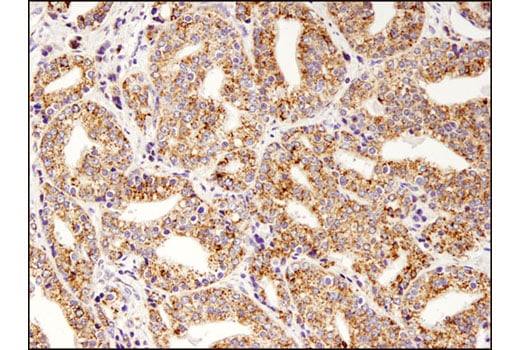
undefined Image 28: Glutamine Metabolism Antibody Sampler Kit

Revision 1
#83718
Store at -20C
Glutamine Metabolism Antibody Sampler Kit
1 Kit
(8 x 20 microliters)
877-616-CELL (2355)
877-678-TECH (8324)
3 Trask Lane | Danvers | Massachusetts | 01923 | USA
For Research Use Only. Not for Use in Diagnostic Procedures.
| Product Includes | Product # | Quantity | Mol. Wt | Isotype/Source |
|---|---|---|---|---|
| ASCT2 (D7C12) Rabbit Monoclonal Antibody | 8057 | 20 µl | 49, 75 kDa | Rabbit |
| GFAT1 (D12F4) Rabbit Monoclonal Antibody | 5322 | 20 µl | 80 kDa | Rabbit IgG |
| GFAT2 (D40C7) Rabbit Monoclonal Antibody | 6917 | 20 µl | 78 kDa | Rabbit IgG |
| Glutaminase-1/GLS1 (E9H6H) Rabbit Monoclonal Antibody | 56750 | 20 µl | 55-65 kDa | Rabbit IgG |
| Glutaminase-2/GLS2 (E9C7V) Rabbit Monoclonal Antibody | 85934 | 20 µl | 60 kDa | Rabbit IgG |
| Glutamate Dehydrogenase 1/2 (D9F7P) Rabbit Monoclonal Antibody | 12793 | 20 µl | 52 kDa | Rabbit IgG |
| GOT1 (E4A4O) Rabbit Monoclonal Antibody | 34423 | 20 µl | 41 kDa | Rabbit IgG |
| Asparagine Synthetase (E6C2C) Rabbit Monoclonal Antibody | 92479 | 20 µl | 64 kDa | Rabbit IgG |
| Anti-rabbit IgG, HRP-linked Antibody | 7074 | 100 µl | Goat |
Please visit cellsignal.com for individual component applications, species cross-reactivity, dilutions, protocols, and additional product information.
Description
Storage
Background
GFAT1, glutamine:fructose-6-phosphate aminotransferase 1, is the rate-limiting enzyme of the hexosamine biosynthesis pathway (7). This enzyme catalyzes the conversion of fructose-6-phosphate and glutamine to glucosamine-6-phosphate and glutamate (8). The hexosamine biosynthesis pathway generates the building blocks for protein and lipid glycosylation (8). Furthermore, studies suggest that increased activity of this pathway is a contributing factor to hyperglycemia-induced insulin resistance (7,8). GFAT1 is more active in non-insulin-dependent diabetes mellitus (NIDDM) patients (9). Transgenic mice overexpressing this enzyme in skeletal muscle and adipose tissue show an insulin resistance phenotype (10,11). GFAT2, an isoenzyme of GFAT1, was later identified (12,13). Studies show that the regulation of GFAT2 is different from that of GFAT1, suggesting differential regulation of the hexosamine pathway in different tissues (13).
Glutaminase catalyzes the conversion of glutamine to glutamate, the first and rate-limiting step of glutaminolysis (14). Both kidney-type glutaminase (GLS1) and liver-type glutaminase (GLS2) are found in mammals (15). GLS1-mediated glutathione synthesis plays an essential role in redox homeostasis and contributes to increased survival of postimplantation bone cells preconditioned to the hypoxic and ischemic environment in the bone defect site (16). In addition, KEAP1–NRF2-mutant LUAD (KRAS-mutant lung adenocarcinoma) tumors are dependent on increased glutaminolysis (14). Furthermore, recent studies showed higher glutaminolysis and glucose production from glutamine in human primary hepatocytes with GLS2 gain-of-function missense mutations (17). These findings suggest GLS1 and GLS2 as potential targets in the therapy of bone regeneration and in the treatments of diseases such as cancer and hyperglycemia, respectively (14,16,17).
Glutamate dehydrogenase is a mitochondrial enzyme that catalyzes the oxidative deamination of glutamate to α-ketoglutarate through association with the cofactor nicotinamide adenine dinucleotide phosphate (18). Glutamate dehydrogenase is highly expressed in various tissues such as the liver, brain, kidney, heart, pancreas, ovaries, and testis. Two isoforms produced by two distinct genes are found in mammalian tissues. The GLUD1 gene is ubiquitously expressed (19), while the GLUD2 gene is specifically expressed in testicular tissues and astrocytes (20,21). Glutamate dehydrogenase links glutamate to the Krebs cycle, thereby playing a critical role in the regulation of energy homeostasis. Research studies have shown that changes in glutamate dehydrogenase activity in pancreatic β-cells can cause a hyperinsulinism syndrome (22).
Glutamate oxaloacetate transaminase 1 (GOT1) catalyzes the interconversion of aspartate and oxaloacetate (23).
Asparagine synthetase (ASNS) catalyzes the synthesis of asparagine from aspartate and glutamine (24). In subsets of gastric and hepatic cancers, ASNS promoter hypermethylation correlates with low ASNS expression, sensitizing these cancers to the asparaginase treatment (25).
Background References
- Utsunomiya-Tate, N. et al. (1996) J Biol Chem 271, 14883-90.
- Bröer, S. (2008) Physiol Rev 88, 249-86.
- Bode, B.P. et al. (2002) Am J Physiol Gastrointest Liver Physiol 283, G1062-73.
- Fuchs, B.C. et al. (2007) Am J Physiol Cell Physiol 293, C55-63.
- Nicklin, P. et al. (2009) Cell 136, 521-34.
- Marin, M. et al. (2003) J Virol 77, 2936-45.
- Niimi, M. et al. (2001) J Hum Genet 46, 566-71.
- DeHaven, J.E. et al. (2001) Diabetes 50, 2419-24.
- Yki-Järvinen, H. et al. (1999) Life Sci 65, 215-23.
- Cooksey, R.C. et al. (1999) Endocrinology 140, 1151-7.
- Hebert, L.F. et al. (1996) J Clin Invest 98, 930-6.
- Oki, T. et al. (1999) Genomics 57, 227-34.
- Hu, Y. et al. (2004) J Biol Chem 279, 29988-93.
- Romero, R. et al. (2017) Nat Med 23, 1362-1368.
- Aledo, J.C. et al. (2000) Mamm Genome 11, 1107-10.
- Stegen, S. et al. (2016) Cell Metab 23, 265-79.
- Miller, R.A. et al. (2018) Nat Med 24, 518-524.
- Blumenthal, K.M. et al. (1975) J Biol Chem 250, 3644-54.
- Michaelidis, T.M. et al. (1993) Genomics 16, 150-60.
- Shashidharan, P. et al. (1997) J Neurochem 68, 1804-11.
- Zaganas, I. et al. (2012) Neurochem Int 61, 455-62.
- Karaca, M. et al. (2011) Neurochem Int 59, 510-7.
- Zhou, X. et al. (2018) BMC Cancer 18, 559.
- Zhang, J. et al. (2014) Mol Cell 56, 205-218.
- Li, H. et al. (2019) Nat Med 25, 850-860.
Trademarks and Patents
Cell Signaling Technology is a trademark of Cell Signaling Technology, Inc.
All other trademarks are the property of their respective owners. Visit cellsignal.com/trademarks for more information.
Limited Uses
Except as otherwise expressly agreed in a writing signed by a legally authorized representative of CST, the following terms apply to Products provided by CST, its affiliates or its distributors. Any Customer's terms and conditions that are in addition to, or different from, those contained herein, unless separately accepted in writing by a legally authorized representative of CST, are rejected and are of no force or effect.
Products are labeled with For Research Use Only or a similar labeling statement and have not been approved, cleared, or licensed by the FDA or other regulatory foreign or domestic entity, for any purpose. Customer shall not use any Product for any diagnostic or therapeutic purpose, or otherwise in any manner that conflicts with its labeling statement. Products sold or licensed by CST are provided for Customer as the end-user and solely for research and development uses. Any use of Product for diagnostic, prophylactic or therapeutic purposes, or any purchase of Product for resale (alone or as a component) or other commercial purpose, requires a separate license from CST. Customer shall (a) not sell, license, loan, donate or otherwise transfer or make available any Product to any third party, whether alone or in combination with other materials, or use the Products to manufacture any commercial products, (b) not copy, modify, reverse engineer, decompile, disassemble or otherwise attempt to discover the underlying structure or technology of the Products, or use the Products for the purpose of developing any products or services that would compete with CST products or services, (c) not alter or remove from the Products any trademarks, trade names, logos, patent or copyright notices or markings, (d) use the Products solely in accordance with CST Product Terms of Sale and any applicable documentation, and (e) comply with any license, terms of service or similar agreement with respect to any third party products or services used by Customer in connection with the Products.
Revision 1



Revision 1



Revision 1



Revision 1



Revision 1



Revision 1



Revision 1



Revision 1



Revision 1



Revision 1

Revision 1



Revision 1



Revision 1



Revision 1



Revision 1

